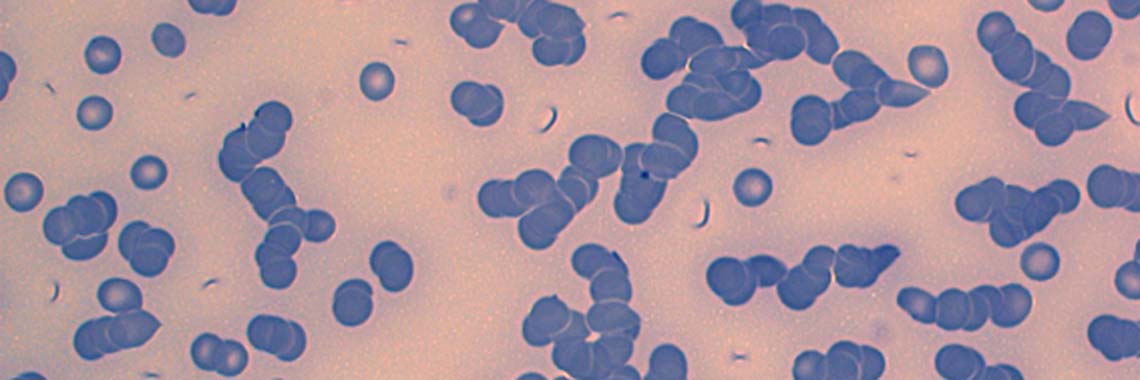

Anfrage
Sie haben Fragen oder ein Anliegen?
Schreiben Sie uns eine kurze Nachricht, wir melden uns umgehend bei Ihnen zurück!
(Bestellungen von Publikationen biite über die Seite "Publikationen" !)
Ihre Daten werden ausschließlich zum Zwecke der Kontaktanfrage gespeichert.
Eine Weitergabe an Dritte erfolgt nicht! Es gelten die Hinweise zum Datenschutz.
* = Angabe erforderlich